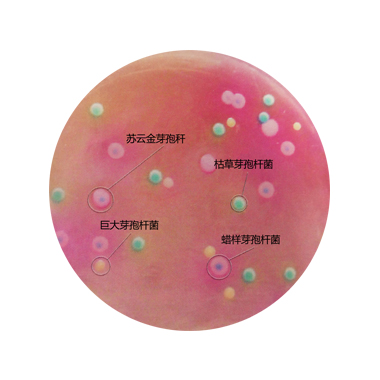
引起食物中毒的芽孢杆菌

串珠试验图片

美国75名科学家存在感染炭疽杆菌风险 事故原因待查
图片尺寸634x476
孩派儿童手工课珠益智女孩玩具弱视训练穿珠子手链项链diy串
图片尺寸500x500
你注意到过这种的珠链吗 | play
图片尺寸1279x720
技术干货详解5类自闭模型行为学检测方法
图片尺寸299x212串珠试验的手绘图所以大数据能推给大佬们看看画对了莫做了自己手指的
图片尺寸1080x909
炭疽可以治疗吗?青霉素依然是治疗的首选药物
图片尺寸498x423
北京报告1例肺炭疽病例 病例已在医院隔离治疗
图片尺寸543x370
引起食物中毒的芽孢杆菌
图片尺寸380x380
丁香园论坛
图片尺寸1040x780
炭疽病是什么感染炭疽杆菌后有什么症状怎么预防炭疽杆菌
图片尺寸1129x848
炭疽杆菌菌落及菌体图片
图片尺寸390x371
竹节倒松卷发样,ascoli 串珠禁解剖.
图片尺寸640x480
罕见胸水中竟然发现胆固醇结晶
图片尺寸600x723
中国结串珠手链
图片尺寸310x310
一,炭疽病
图片尺寸600x372
青霉素串珠试验为阳
图片尺寸663x663
于血琼脂平板和碳酸氢钠琼脂平板,孵育后观察菌落,用青霉素串珠试验
图片尺寸1080x720
精液检查标准值
图片尺寸583x329
2013实验三,细菌芽孢及荚膜染色观察
图片尺寸1080x810
炭疽-军事医学-医学
图片尺寸713x491
猜你喜欢:串珠试验炭疽杆菌串珠试验串珠试验手绘图炭疽杆菌串珠试验图片各种串珠图片大全图片串珠图片欣赏图片大全串珠图片手工串珠图片彩色串珠图片串珠手链图片幼儿串珠图片小米珠串珠法大全图片幼儿园串珠图片手工串珠图片作品手工串珠图解108串珠搭配图片串珠手链图片教程肋骨串珠图片大全串珠图解60个手工串珠图片小动物手持串珠的搭配图片好看的串珠手链图片串珠纸巾盒花图片大全串珠简单串珠手工串珠婴儿肋骨串珠的图片串珠打结方法图解串珠教程串珠手工活十二星座的头像可爱硬笔书法老师简历模板鸡叫卡通梦幻背景樱花飘落看图找隐藏的人头图片星骸骑士 动画清纯女生短发扬子江头杨柳春慵懒惬意的图片自学正骨图解 手法永远常在口琴谱出海渔民